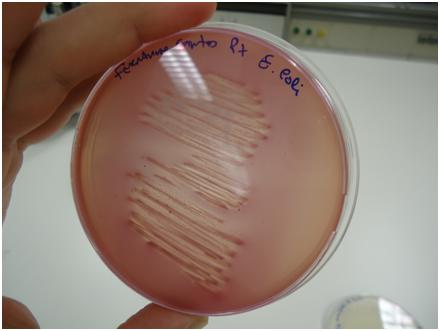
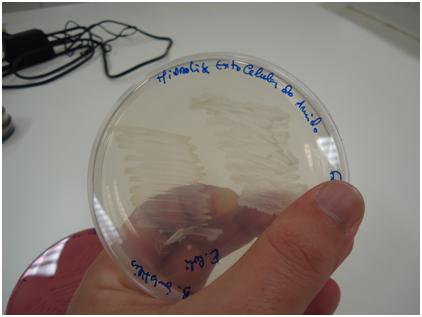

| Procedimentos do meu trabalho. |
06/12/2012 |
Para se obter uma cultura pura em laboratório podemos proceder à técnica do riscado. Os microrganismos que pretendemos isolar são semeados em meio de cultura sólido em caixa de Petri. Após desenvolvimento de colónias, cada uma formada por crescimento e divisão de uma única célula, a transferência de uma colónia isolada para novo meio de cultura vai originar uma cultura pura.
Os microrganismos para o seu crescimento necessitam de nutrientes (fontes de carbono, azoto, fósforo e todos os outros elementos essenciais), de energia (luz ou energia química obtida a partir da oxidação de compostos orgânicos ou inorgânicos) e de condições ambientais adequadas. Meios de cultura são soluções aquosas contendo vários nutrientes que permitem o crescimento dos microrganismos. Dois tipos básicos de meios de cultura podem ser usados: complexos (composição química não definida) e sintéticos (quimicamente definido). Os meios complexos possuem na sua composição nutrientes como extratos de carne ou de levedura, ricos em vitaminas, aminoácidos e minerais, e outros constituintes como peptonas. A peptona é constituída por polipéptidos de vários tamanhos e aminoácidos resultantes da digestão enzimática da carne por enzimas pancreáticas. Muitos meios complexos são comercializados numa forma desidratada e para a sua preparação apenas é necessário adicionar água.
Depois de adicionado o meio de cultura específico e o agar, o meio, ainda quente é colocado numa placa de Petri onde em Camara de Fluxo Laminar ou com a presença de uma Lamparina, para não haver contaminação aérea, é devidamente arrefecido e solidificado onde seguidamente o inoculo, ou seja, uma amostra de fezes de pombo homogeneizada e hidratada, com a ajuda de uma ansa estéril é transferido para a placa.
Aspecto final da preparação em meio específico e selectivo, ou seja, o meio utilizado inibe o crescimento da maior parte das bactérias microbiota normal do pombo, ou seja Gram Positivos e fornece o crescimento de Enterobactérias, ex. Salmonella, E.coli, incluindo também Pseudomonas.
Nesta imagem vemos o crescimento em massa de uma bactéria, lactase positiva, ou seja, fermentadora da lactose. Vemos também a precipitação dos sais biliares.
Nota: Incubação de 24 horas.
A zona central, com aspecto de riscado é o crescimento abrupto de bactérias. Depois de transferida para uma nova Petri já com novo meio, foi isolado o seu crescimento:
O riscado da direita, foi a bactéria transferida da cultura acima, o da esquerda é outra bactéria do tipo Gram +. Mais 24 horas de incubação para este meio.
No passo seguinte adicionamos um reagente que nos diz que se a bactéria degrada o amido ou não.
A bactéria do lado direito não degradou o amido e a da esquerda sim, chegamos a esta conclusão porque o reagente cora o amido, se há presença é porque não foi degradado.
Então temos uma bactéria Gram Negativa Fermentadora de Lactose não degradadora de Amido.
Agora, com a bactéria isolada e sendo ela uma Enterobactéria fazemos 20 testes bioquímicos.
Retiramos um pouco da cultura, homogeneizamos em 5 ml de água destilada estéril e colocamos umas gotas em cada compartimento de cada reagente:

Depois de 24 horas em estufa microbiológica a 37º ou seja temperatura corporal fazemos o controlo positivo ou negativo, esta amostra P7 deu o seguinte controlo:

Olhando para os números obtemos a seguinte sequência: 5144552
Auxiliamos com o manual e obtemos a seguinte bactéria:

Temos assim identificada a nossa bactéria com 99,9% de exactidão.
Não se resume a um só “esfregaçozito”, como vários columbófilos o mencionam.
Espero ter elucidado acerca desta matéria pois é sempre bom as pessoas saberem como se trabalha em laboratório.
A amostra está identificada com o meu nome para não revelar o nome do columbófilo que agora já tem o seu problema resolvido.
FERNANDO ADALBERTO RODRIGUES DOS SANTOS
TEL. +351 963 183 242
MAIL: vet.fernando@sapo.pt
|